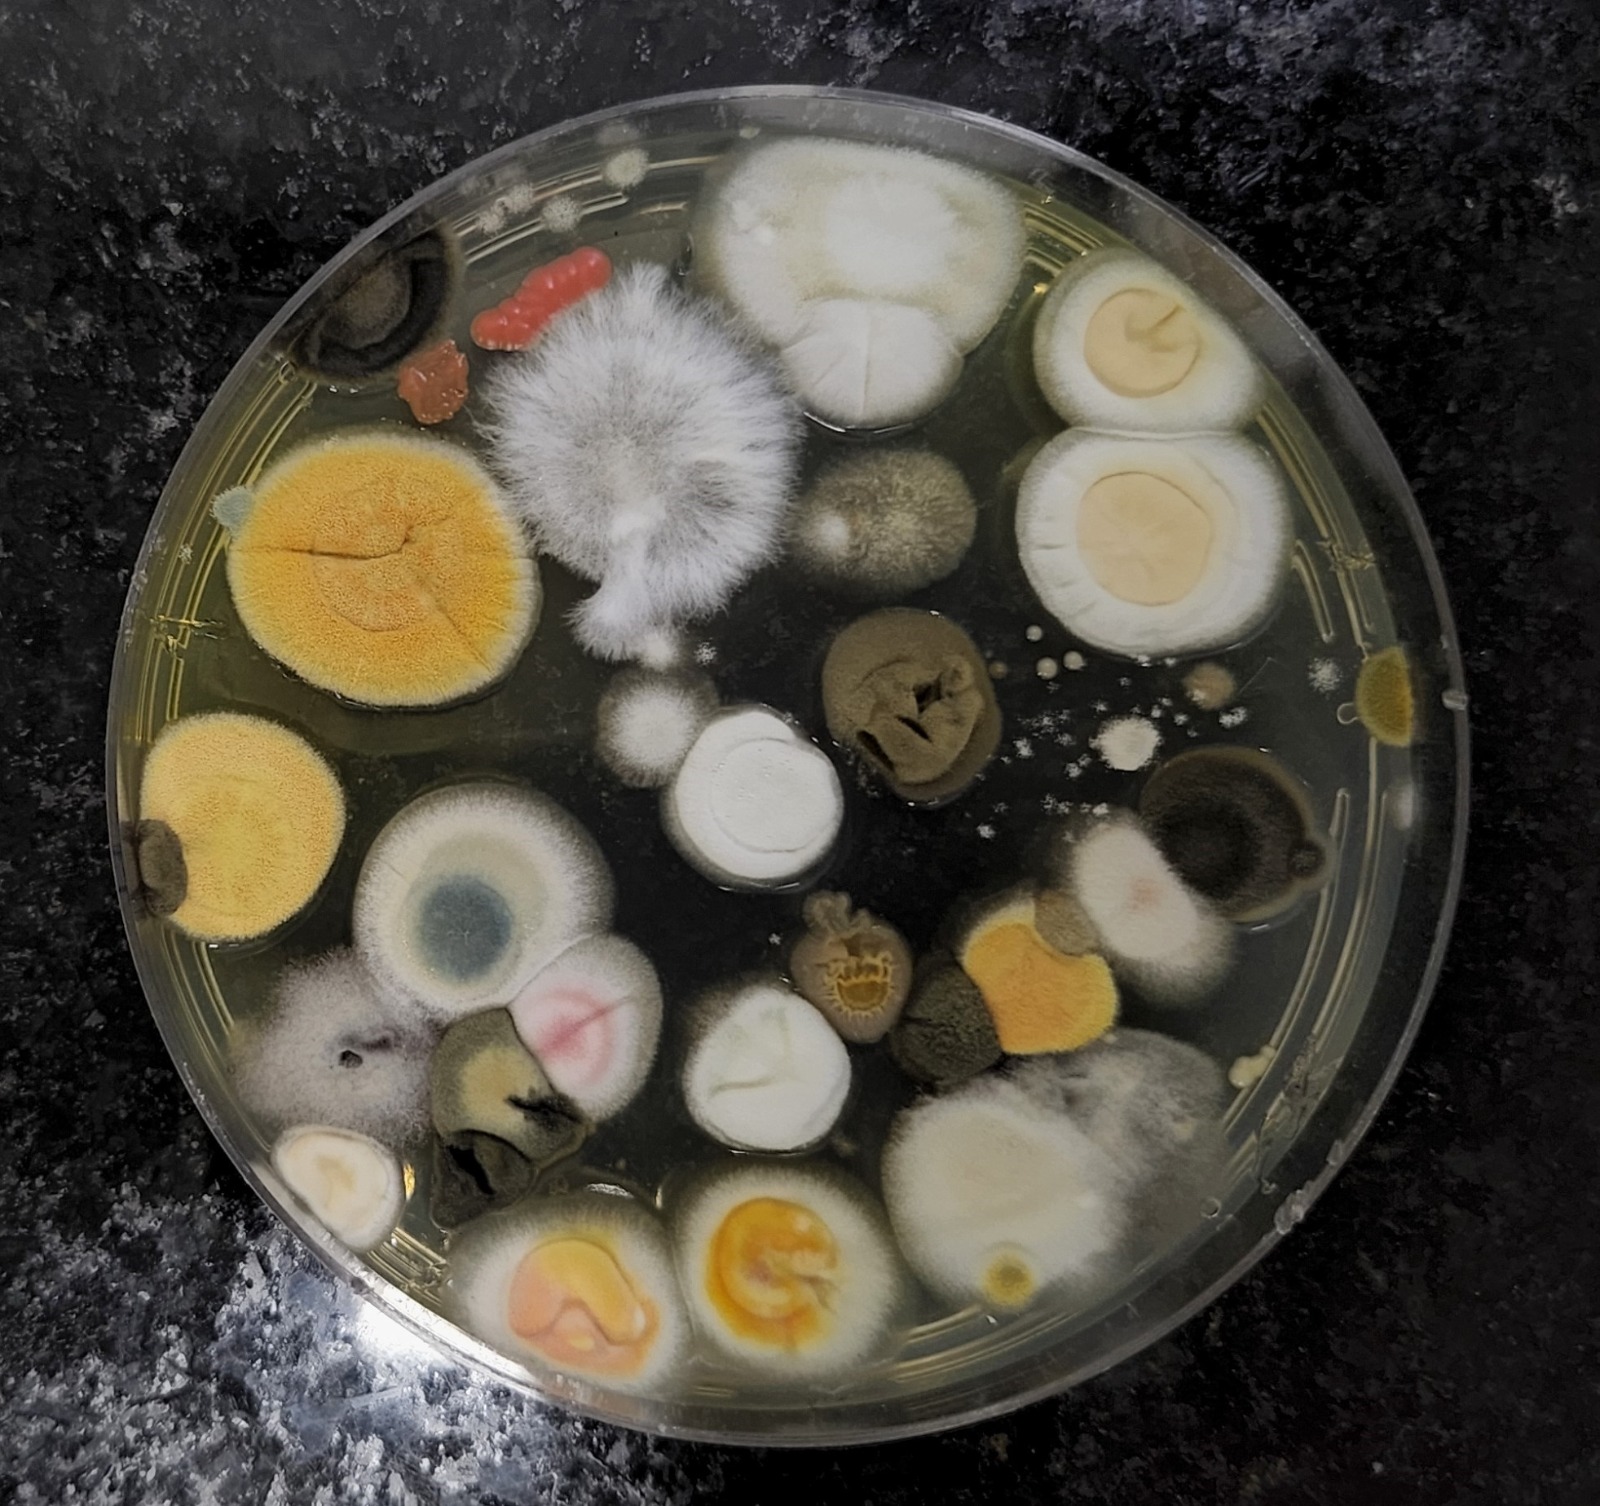

Pesquisa inédita impulsiona manejo e desenvolvimento sustentável

Uma nova pesquisa vai desvendar a biodiversidade dos fungos no Cerrado e Pantanal, ampliando a possibilidade de desenvolvimento sustentável da bioeconomia e a inovação tecnológica. Com financiamento de R$ 3,7 milhões, sendo R$ 1,2 milhão da Fundação de Amparo à Pesquisa do Estado de Goiás (Fapeg) e R$ 2,5 milhões da Capes, o projeto busca construir um inventário detalhado de fungos associados a diversos ecossistemas da região Centro-Oeste.
Liderada pela pesquisadora Célia Maria de Almeida Soares, da Universidade Federal de Goiás (UFG), a pesquisa será desenvolvida em rede, conectando 18 instituições nacionais e internacionais. O projeto faz parte do Programa de Desenvolvimento da Pós-Graduação (PDPG Centro-Oeste), voltado para bioeconomia, biotecnologia e biodiversidade, com conclusão prevista para 2029.
Segundo Célia Soares, o estudo vai gerar informações valiosas para o desenvolvimento biotecnológico nas áreas da medicina, agricultura e processos industriais. “Os fungos são essenciais para a vida na Terra. Conhecê-los é fundamental para enfrentar desafios ambientais e de saúde humana, especialmente diante das mudanças climáticas”, explica.
Manejo sustentável
Já foram iniciadas as coletas em Goiás e Mato Grosso do Sul. O inventário produzido será uma ferramenta decisiva no manejo sustentável e conservação da biodiversidade local. Além disso, os resultados poderão impulsionar a criação de medicamentos, desenvolvimento de enzimas industriais e soluções biotecnológicas para o setor agrícola, gerando impacto direto na economia regional e na qualidade de vida da população.
Além dos benefícios diretos, o projeto prevê a formação e capacitação de profissionais especializados, fortalecendo os programas de pós-graduação envolvidos e contribuindo para o desenvolvimento científico e tecnológico da região. A cooperação internacional ainda ampliará o alcance e impacto da pesquisa, permitindo a troca de conhecimento e a incorporação de tecnologias avançadas no desenvolvimento do estudo.